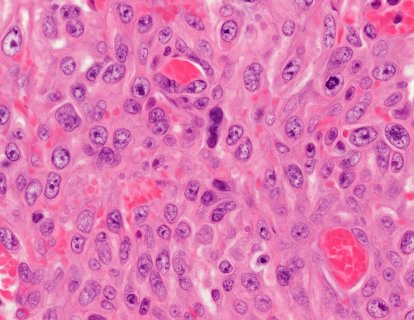
Sarkom Tanısında Histopatoloji, İmmünohistokimya ve Moleküler Tanı Birlikte Ne Anlatıyor?

Bu bölüm nadiren görülen kanser türleri ile ilgilidir. Ne oldukları, farklı türleri ve bunların tedavileri hakkında bilgiler içermektedir. Ayrıca bu kanserler hakkında devam eden araştırmalar ve nadir bulunan bir kanserin nasıl tedavi edildiği hakkında da bilgi vardır. Aradığınız kanser türü hakkında burada bilgi bulamazsan, web sitemizde başka yerlerde bilgi olup olmadığını kontrol etmek için arama kutusunu kullanabilirsiniz. Ayrıca, aradığınız bilgiye ulaşamazsanız bizimle de iletişime geçebilirsiniz.
Nadir kanserler için sık görülen kanserlerin alt türleridir denebilir.
Doktorlar ve araştırmacılar olarak kanser hakkındaki bilgimiz arttıkça, belli özelliklerine ve farklılıklarına göre kanserlerin alt tiplerini tanımıyoruz. Bu sınıflama doğru tedaviyi seçmemizde bazen en büyük yardımcımız olmaktadır. İşte bu alt tiplerin bazıları nadir görülür.
Bazı kanser alt türleri farklı şekilde tedavi edilir. Örneğin, meme anjiyosarkomu çoğu diğer meme kanserlerinden farklı şekilde tedavi edilir. Durum bu olduğunda, bunları nadir kanserler listemize dahil edeceğiz.
Nadir bulunan kanser listemizde aradığınız kanserin tam adını bulamazsanız, bu ana kategorisindeki kanser türüyle aynı şekilde tedavi edildiğinden kaynaklanabilir (sık görülen kanser türlerinin tedavisine buradan ulaşabilirsiniz). Örneğin, over (yumurtalık) kanserinin seröz, endometrioid, berrak ve müsinöz olmak üzere birçok alt tipi vardır. Ancak hepsi aynı şekilde tedavi edilir ve normal yumurtalık kanseri bölümümüzdeki tüm bilgiler size uygulanır.
Bir belirti veya şikayetin kansere ait olup olmadığına karar vermek, özellikle nadir görülen kanserler için oldukça zor olabilir. Kansere bağlı bulgu ve şikayetler diğer tıbbi durumdakilere çok benzer.
Bazı onkologlar, nadir bulunan kanser türleri veya ender alt kanser türlerinde ileri uzmanlığa sahiptir. Nadir bir kansere sahip olan kişilerin çoğu doğal olarak başlangıçta en kolay ulaştıkları kanser uzmanına başvurabilirler. Ancak, ender rastlanan kanser türlerini tedavi etmede uzmanlaşmış başka bir kanser doktoru varsa, yerel kanser doktorunuz onlara danışabilir veya sizi yönlendirebilir.
Nadir görülen konserlerin kendilerine özgü belirtileri çoğu zaman olmadığı için köken aldıkları organ kanserlerinin genel belirtilerine bakıp bu konuda fikir edinebilirsiniz (bakınız kanser belirtileri bölümü).
Vücudunuzu tanımak ve sizin için normal olmayan bir değişiklik fark ederseniz doktorunuza bildirmek önemlidir.
Kanserin erken fark edilmesi, tedavinin başarılı olmasının muhtemel olduğu anlamına gelir...
Nadir görülen kanserler hakkında Türkçe çok az kaynak bulunmaktadır. Aşağıdaki yazılarımızla, bu konudaki eksikliği gidermeyi hedefledik.

🧬 Sarkomlarda Yeni Bir Dönem: ctDNA ile MRD Takibi Sarkomlar,

🔬 Sarkomlar: Nadir Ama Ciddi Kanserler Sarkomlar, vücudun bağ dokularından
🔍 Sarkom Tanısında Neden Uzmanlık ve Detay Önemlidir? Sarkomlar, vücudun

Goblet Cell Adenokarsinomu (GCA), genellikle apandiste (kör bağırsağın başlangıç kısmı)

Schwannomatozis, sinir sistemi tümörlerinin gelişimine yol açan nadir bir genetik

Sinovyal sarkom, genellikle genç yetişkinleri etkileyen ve tedavisi zor bir

Adrenal bezler, böbreklerin üstünde bulunan endokrin (hormonal) bezlerdir ve kortizol,

Dermatofibrosarkom Protuberans Nedir? Dermatofibrosarkom protuberans, deri altı dokunun nadir görülen

Teratom, farklı doku türlerini içerebilen nadir bir tümördür ve germ

Özgeçmişim, kanser tanı ve tedavisine dair çalışmalarım ve ilgi alanlarım için tıklayın.

Kayıt Oldunuz!
Kayıt işleminiz başarı ile gerçekleştirildi, giriş yapabilirsiniz. E-Posta adresinizi doğrulamayı unutmayın!